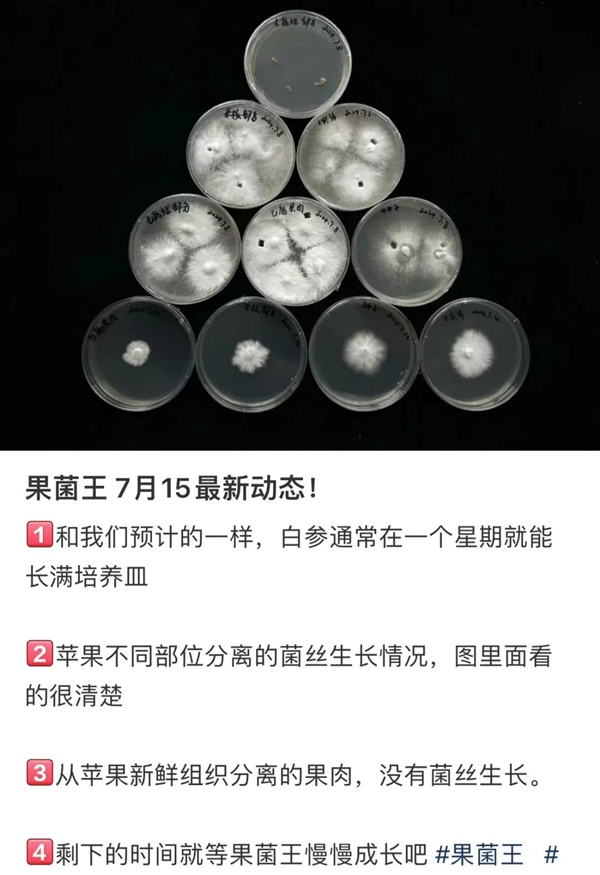

2024 年 7 月,浙江德清县的邓女士在网上发帖称,她家里一颗遗忘多日的苹果“发霉”了,竟然长出了蘑菇!

来源:某社交平台@沛容
从她提供的照片可以看到,苹果外表基本完好,但顶部却冒出了几朵白色的蘑菇。这一现象让人感到非常惊讶,因为大多数蘑菇只能在土壤和腐木上生长,以腐烂的有机质为营养。这个苹果看起来还是好的,怎么会长出蘑菇呢?
没过多久,邓女士就收到中国科学院昆明植物研究所在读博士的私信,称其想买下苹果做研究。后续邓女士按博士交代的,把苹果用保鲜膜包起来放到冰箱,第二天和冰袋一起放在泡沫箱,无偿寄到了中国科学院昆明植物研究所。
看到这段跌宕起伏的经历,网友感叹这个苹果终于得以发挥科研价值的同时,评论区也是一片欢乐,有网友还戏称它是“果菌王”……

来源:某社交平台@沛容
那为什么之前没见过别的苹果长蘑菇呢?这种蘑菇到底有什么科研价值?今天我们就来了解一下。
苹果上的蘑菇是什么?
研究人员通过进一步的测序鉴定,发现这个蘑菇是裂褶菌(Schizophyllum commune),它是裂褶菌属的模式种,也是该属最常见的物种,生命力极为顽强,广泛分布于世界各地。几乎全年任何时候,你都能在野外的树枝和木桩上发现它们的踪迹。
裂褶菌因其独特的纵向开裂的菌褶而得名,通常喜欢生长在枯萎、腐烂的木头上,具有很强的木质素分解能力,是一种腐生菌。
此外,裂褶菌也被认为是一种植物病原菌,菌丝活性极强,可以侵染苹果、柑橘和橄榄等活树,导致木材腐烂、树皮变黑、叶片坏死。这种木腐病害主要发生在老化和抗病能力较弱的树木上,国内外都有苹果树感染裂褶菌的报道。
因此,一种合理的假设是,裂褶菌最初侵染了苹果树,使其携带了裂褶菌的孢子或菌丝,在环境条件适宜时(如梅雨季节),便在苹果上生长出来。

野外生长的裂褶菌。来源:作者
随着“果菌王”引起热议,一些网友更是晒出了其他基质上生长的裂褶菌,其中最为独特的是大蒜上长出的裂褶菌。不少人就产生了疑问,大蒜不是杀菌的吗?怎么还能长蘑菇呢?
其实,这和大蒜为什么会发霉是同一个问题。大蒜的主要抗菌活性成分是大蒜素,但大蒜素并不是自然存在于大蒜细胞中,只有通过机械外力破坏大蒜的组织结构,其体内的蒜氨酸和蒜氨酸酶才能结合形成大蒜素。
真菌的菌丝侵入不会对组织细胞产生明显损坏,因此只能产生微量的大蒜素,并不足以抵御真菌的入侵。所以,大蒜的抗菌性并不能防止自身的腐烂,也不能防止裂褶菌的侵染。

图源:参考文献[5]
不易腐败的苹果为什么长蘑菇?
其实,将这颗长蘑菇的苹果切开之后可以看到,菌丝已经侵染了苹果的内部,并逐渐向外扩张地盘。这颗苹果内部已经明显的腐烂。仔细观察苹果顶部长蘑菇的地方,其实在表皮上还是能发现这个看似完整的苹果已经有了变质的痕迹。

来源:某社交平台@我真的不能再喝了
食品腐败是由细菌和各种真菌造成的,这些微生物在分解食物时,会产生各种废物,可能会对人体健康有害,例如喜欢在谷物上大量繁殖的黄曲霉(Aspergillus flavus),其产生的黄曲霉素被认为是最具毒性和最强的肝致癌性天然化合物。
生活经验告诉我们,苹果是一种非常耐储藏的水果,有时放置几个月也不会变质,只是会失去水分而变得干瘪。那这个苹果为什么会这样呢?
原来,苹果在生长过程中会分泌一层果蜡,能够有效防止外界微生物侵入果肉。然而,苹果的果梗凹陷处是一个薄弱点,能够直接通向果核,因此最容易被微生物侵入,裂褶菌也选择了这个地方生长。

苹果的形态 图源:参考文献[6]
如果细心观察的话,你会发现,自然界的蘑菇喜欢在木头的缝隙处生长,最好是有伤口的地方,这便于蘑菇菌丝侵入基质内部。
因此有伤口的苹果以及其他水果都要尽快吃掉,不然更容易坏。在日常保存苹果的时候,可以将其放入冰箱中冷藏,低温可以抑制微生物的生长,延长保存时间。
苹果是可以吃的,裂褶菌也是可以吃的,那么长了裂褶菌的苹果还可以吃吗?答案是否定的!食物的腐败是多种微生物参与的,尽管裂褶菌可能占据了主要优势,但很可能有其他的细菌和真菌存在,它们在代谢的过程中产生的物质有可能危害健康。
退一步讲,就算苹果中只有裂褶菌存在,食用布满裂褶菌菌丝的苹果那不相当于生吃蘑菇了?还是不推荐的。
原来我们早就吃过裂褶菌!
早在 2000 以前,我国云南民间就有采食裂褶菌的习惯,老百姓形象的称之为“白参”。经典的做法是“白参蒸鸡蛋”,也可直接炒食,美味又滋补,但口感偏硬,都需要提前泡发。
在墨西哥、印度等地的人也有食用裂褶菌的习惯。裂褶菌相比于其他食用蘑菇一个优势在于,它质地坚硬而有弹性,不容易腐烂,便于远销。目前,由于人工栽培的产量有限,裂褶菌的价格较高,干品售价能达到 50 元/斤。

腐木裂缝中生长的裂褶菌 图源:参考文献[7]
经过研究人员的亲自品尝,在苹果上长出的裂褶菌并没有苹果味。其实这个结果也是可想而知的。
蘑菇里面的风味物质包括非挥发性游离氨基酸、可溶性糖、呈味核苷酸等,挥发性风味物质包括的含硫化合物及醇、酮类化合物、醛类、酯类等,这些物质的生成是由基因控制的,苹果中的风味物质也是如此。
在不同生长基质中,由于环境条件的差异,同一种蘑菇分泌的这些风味物质可能有多有少,从而影响蘑菇的味道,但不太可能导致产生这些风味物质的基因发生改变,更不要说定向拥有产生苹果风味物质的基因了。
举一个植物里面的例子:有一些西瓜会嫁接到南瓜的秧上,这是利用南瓜发达的根系,吸收土壤里面更多的养分以供西瓜生长,这样结出来的西瓜会更好吃,但是不会有南瓜味。
研究人员为什么收集苹果上的裂褶菌?
食用菌育种的目标是为了获得高产、优质、高抗和生物活性物质含量高的优良品种。在自然条件下,一些野生的食用菌会发生变异,而有益的变异通过不断累积利用,就能获得人们需要的新品种。
这种重要的育种方式称为“人工选择育种”,优良香菇(Lentinula edodes)品种 7401、广香 5 号、241 和 8210 等均是通过人工选择法筛选得到的,这也是为什么做食用菌栽培的研究人员会广泛收集单一物种的野生食用菌资源。
目前可以明确的是,这颗苹果上生长的裂褶菌菌丝活性强,生长速度快,接下来需要进行栽培实验看是否高产。其实对于裂褶菌来说,可能更重要的还是选育出没那么硬的品种,那么接下来还需要评价下它的口感。
来源:某社交平台@我真的不能再喝了
在食用菌育种技术里面有一种更为高效的方法——辐射诱变育种,它是利用物理或化学诱变剂处理细胞群体,提高其突变率,然后从群体中选出符合育种目标的突变株。
裂褶菌的菌丝就多次上过太空,利用太空辐射来改变遗传特性,从而选育出了市场上口感更好的裂褶菌。
值得注意的是,裂褶菌同时也是一种常见的人类病原菌,它感染人之后和霉菌的形态是类似的。大多数病例涉及呼吸道,包括支气管肺疾病和鼻窦炎,无论是在免疫功能正常还是低下的人群中均有发生。
这警醒我们在采集和处理裂褶菌的时候,不要放在鼻子下去闻,以防吸入裂褶菌孢子。
参考文献
[1]卯晓岚, 2000. 中国大型真菌. 河南科学技术出版社.
[2]于梓芃,李宁阳,弓志青,等.食用菌呈味物质及其检测技术、应用的研究进展[J].食品工业科技,2024,45(02):373-379.DOI:10.13386/j.issn1002-0306.2023020269.
[3]付立忠,吴学谦,魏海龙,等.我国食用菌育种技术应用研究现状与展望[J].食用菌学报,2005,(03):63-68.DOI:10.16488/j.cnki.1005-9873.2005.03.012.
[4]Chowdhary A, Kathuria S, Agarwal K, et al. Recognizing filamentous basidiomycetes as agents of human disease: a review[J]. Medical Mycology, 2014, 52(8): 782-797.
[5]https://mp.weixin.qq.com/s/kvbog7_IoIEyPBRx1iVEog
[6]https://en.wikipedia.org/wiki/Apple
[7]https://en.wikipedia.org/wiki/Schizophyllum_commune
策划制作
作者丨饶固 南京师范大学生命科学学院
审核丨曾辉 福建省农业科学院食用菌研究所所长
策划丨符思佳
责编丨一诺
审校丨徐来、林林
– THE END –







评论0